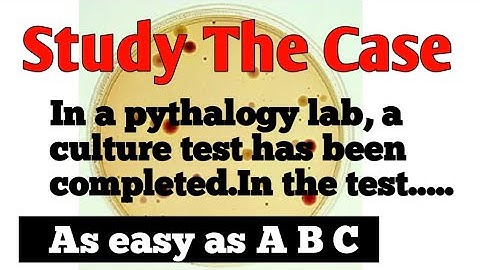
HOW TO SOLVE CASE BASED QUESTION ? ITS AS EASY AS 👉A 👉B👉C

⬇ DOWNLOAD NOW
Kalau muncul iklan pop-up, tutup lalu klik tombol kembali
Download lagu Case Study Based Questions|| Class 10 CBSE||Real Numbers||Rajesh Tutorials secara gratis hanya untuk keperluan promosi. Dukung artis favorit kamu dengan membeli musik original di iTunes atau platform resmi lainnya.
 Case Study Based Question||Class 10||CBSE||Class 10 Maths||Rajesh Tutorials
Case Study Based Question||Class 10||CBSE||Class 10 Maths||Rajesh Tutorials
 Real Numbers | Full Chapter | Super Revision | NCERT CBSE Class 10 Maths | @Rajesh Tutorials
Real Numbers | Full Chapter | Super Revision | NCERT CBSE Class 10 Maths | @Rajesh Tutorials
 Case Study for Class 10 (Real Numbers)
Case Study for Class 10 (Real Numbers)
 Case Study Questions 01| Ch:1 Real Numbers| Class 10
Case Study Questions 01| Ch:1 Real Numbers| Class 10
 Case Study based Questions | Chapter 1 real numbers case study based questions class 10 cbse |
Case Study based Questions | Chapter 1 real numbers case study based questions class 10 cbse |
HOW TO SOLVE CASE BASED QUESTION ? ITS AS EASY AS 👉A 👉B👉C
HOW TO SOLVE CASE BASED QUESTION ? ITS AS EASY AS 👉A 👉B👉C
 "Class 10 Maths Chapter 1 & 2 Case Study Questions with Hints | Real Numbers & Polynomials"2025
"Class 10 Maths Chapter 1 & 2 Case Study Questions with Hints | Real Numbers & Polynomials"2025
 CASE STUDY QUESTIONS CLASS-10 CBSE I CBSE SAMPLE PAPER ICASE STUDY ON REAL NUMBER I BY- R K SAINI
CASE STUDY QUESTIONS CLASS-10 CBSE I CBSE SAMPLE PAPER ICASE STUDY ON REAL NUMBER I BY- R K SAINI